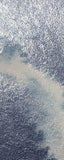

Oi! Obrigado por verificar nossa página do produto!
Nome do produto:Mica em camadas da pintura da aguarela
Marca:Supervisão
Especificação:2ml/cor
Embalagem:Caixa de plástico
Descrição:Tinta autêntica original espremida na caixa, tinta aquarela molhada.
Desejo-lhe uma compra feliz em nossa loja e feliz todos os dias!